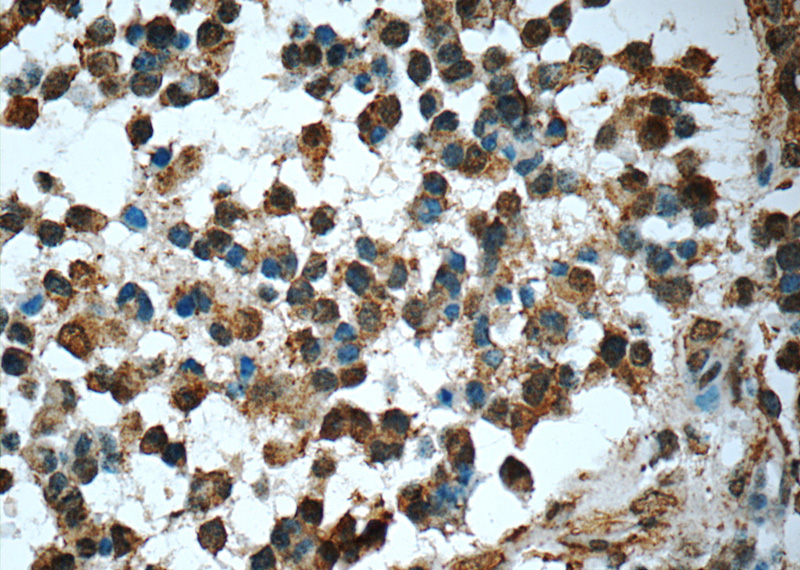
Immunohistochemistry of paraffin-embedded human gliomas tissue slide using Catalog No:107282(FUS/TLS Antibody) at dilution of 1:50 (under 40x lens)

-
Product Name
FUS/TLS antibody
- Documents
-
Description
FUS/TLS Mouse Monoclonal antibody. Positive IF detected in human brain(ALS) tissue. Positive IHC detected in human gliomas tissue, human brain (FTLD) tissue, human ovary tumor tissue. Positive WB detected in K562 cells, HeLa cells, HL-60 cells. Positive IP detected in HeLa cells. Observed molecular weight by Western-blot: 73 kDa
-
Tested applications
ELISA, WB, IF, IHC, IP
-
Species reactivity
Human, Mouse; other species not tested.
-
Alternative names
75 kDa DNA pairing protein antibody; FUS antibody; FUS CHOP antibody; FUS1 antibody; FUS-CHOP antibody; hnRNP P2 antibody; Oncogene FUS antibody; Oncogene TLS antibody; POMp75 antibody; RNA binding protein FUS antibody; TLS antibody; TLS/CHOP antibody
- Immunogen
-
Isotype
Mouse IgG1
-
Preparation
This antibody was obtained by immunization of FUS/TLS recombinant protein (Accession Number: NM_004960). Purification method: Caprylic Acid/Ammonium Sulfate Precipitation.
-
Clonality
Monoclonal
-
Formulation
PBS with 0.1% sodium azide and 50% glycerol pH 7.3.
-
Storage instructions
Store at -20℃. DO NOT ALIQUOT
-
Applications
Recommended Dilution:
WB: 1:500-1:5000
IP: 1:5000-1:50000
IHC: 1:20-1:200
IF: 1:20-1:200
-
Validations

K-562 cells were subjected to SDS PAGE followed by western blot with Catalog No:107282(FUS antibody) at dilution of 1:1000

IF result of McAB FUS(Catalog No:107282) in the Paper

IP Result of anti-FUS/TLS (IP:Catalog No:107282, 4ug; Detection:Catalog No:107282 1:10000) with HeLa cells lysate 920ug.
Immunohistochemistry of paraffin-embedded human gliomas tissue slide using Catalog No:107282(FUS/TLS Antibody) at dilution of 1:50 (under 40x lens)
-
Background
FUS (also named TLS and POMp75) belongs to the RRM TET family. FUS may play a role in the maintenance of genomic integrity; it binds both single-stranded and double-stranded DNA and promotes ATP-independent annealing of complementary single-stranded DNAs and D-loop formation in superhelical double-stranded DNA. FUS is also an RNA-binding protein, and its links to neurodegenerative disease proffer the intriguing possibility that altered RNA metabolism or RNA processing may underlie or contribute to neuron degeneration. Two research groups simultaneously reported that FUS is present in 5% of the pathalogical aggregations (inclusions) seen in familial amyotrophic sclerosis (fALS). FUS-positive inclusions were also reported in cases of sporadic ALS (sALS). More recently, wild-type FUS has also been implicated in the pathological development of frototemporal lobar dementia (FTLD) with ubiquitin-positive inclusions (FTLD-U), further linking FUS to the pathogenesis of neurogenerative diseases. There is some debate as to whether FUS colocalizes with TDP-43 in TDP-43-positive cases of ALS and whether TDP-43 and FUS cause neurodegenerative disease independently or contributively of one another. This antibody is a mouse monoclonal antibody raised against an internal region of human FUS. Initial reports from our customers suggest this new monoclonal FUS antibody (60160-1-Ig) is a useful tool in ALS and FTLD research. For more details, please see our blog article regarding the matter.
-
References
- Yasuda K, Zhang H, Loiselle D, Haystead T, Macara IG, Mili S. The RNA-binding protein Fus directs translation of localized mRNAs in APC-RNP granules. The Journal of cell biology. 203(5):737-46. 2013.
- Lu L, Zheng L, Si Y. Hu antigen R (HuR) is a positive regulator of the RNA-binding proteins TDP-43 and FUS/TLS: implications for amyotrophic lateral sclerosis. The Journal of biological chemistry. 289(46):31792-804. 2014.
- Deng J, Yang M, Chen Y. FUS Interacts with HSP60 to Promote Mitochondrial Damage. PLoS genetics. 11(9):e1005357. 2015.
- McGurk L, Lee VM, Trojanowksi JQ, Van Deerlin VM, Lee EB, Bonini NM. Poly-A binding protein-1 localization to a subset of TDP-43 inclusions in amyotrophic lateral sclerosis occurs more frequently in patients harboring an expansion in C9orf72. Journal of neuropathology and experimental neurology. 73(9):837-45. 2014.
- Neumann M, Valori CF, Ansorge O. Transportin 1 accumulates specifically with FET proteins but no other transportin cargos in FTLD-FUS and is absent in FUS inclusions in ALS with FUS mutations. Acta neuropathologica. 124(5):705-16. 2012.
- Lee EB, Russ J, Jung H. Topography of FUS pathology distinguishes late-onset BIBD from aFTLD-U. Acta neuropathologica communications. 1(9):1-11. 2013.
Related Products / Services
Please note: All products are "FOR RESEARCH USE ONLY AND ARE NOT INTENDED FOR DIAGNOSTIC OR THERAPEUTIC USE"
